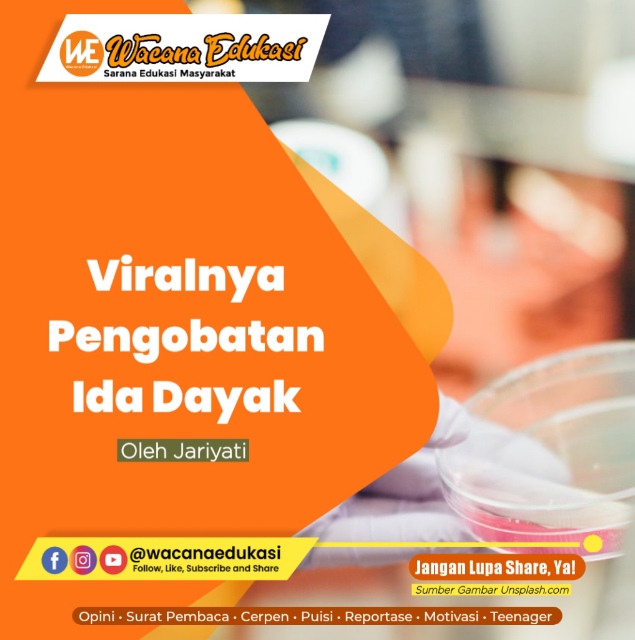

Oleh Jariyati
wacana-edukasi.com, SURAT PEMBACA– Pengobatan tradisional sebetulnya bukanlah hal yang baru, sebut saja Ningsih Tinampil 2019 dan Ponari 2009. Begitupun nama Ida Dayak menjadi viral dan mencuat setelah video rekaman dirinya saat mengobati pasien secara nonmedis tersebar di media sosial.
Saat mengobati pasien, Ida Dayak menggunakan minyak berwarna merah dan sebelum mulai praktik pengobatannya Ida Dayak mengawalinya dengan ritual menari. Ida mampu mengobati
berbagai penyakit mulai dari patah tulang, stroke hingga menyembuhkan pasien tuli dan bisu.
Puncaknya saat Ida Dayak melakukan pengobatan alternatif di gedung olahraga Divif 1 kostrad pada 3-4 April 2023, terjadi kemacetan luar biasa di jalan raya Bogor arah Jakarta di Cilodong, Depok. (Detik.com, 6 April 2023)
Ternyata antusias masyarakat pun luar biasa terkait ingin mencoba pengobatan tradisonal dari Ida Dayak ini. Hal ini terlihat ketika masyarakat rela mengantri dan berdesakan untuk mendapatkan pengobatan tradisional, terutama bagi mereka yang tidak memiliki akses pengobatan modern, ya bisa jadi karena mereka frustrasi dengan pengobatan modern saat ini yang di anggap mahal, tidak terjangkau dan aturan yang rumit.
Pengobatan Modern Mahal & tidak Terjangkau, mengapa?
Tidak mengherankan jika biaya pengobatan modern hari ini bisa dibilang sangat mahal. Mahalnya biaya rumah sakit di negeri ini tidak lain disebabkan karena adanya komersialisasi dalam bidang kesehatan. Karena saat ini, kesehatan dipandang sebagai objek yang bisa dibisniskan. Untuk mendapatkan keuntungan besar, maka dibangunlah sarana dan prasarana kesehatan hanya untuk mengembangkan bisnis. Begitulah, ketika sistem yang diterapkan hari ini memakai sistem kapitalisme. Dimana sitem kapitalisme ini memandang bahwa apapun itu, jika bisa mendatangkan keuntungan maka akan dibisniskan tidak peduli apakah itu menyangkut hajat hidup orang banyakkah, ataukah merugikan masyarakat, dan apakah hal tersebut membuat kesulitan bagi orang lain atau tidak. Dalam hal ini banyak para pengusaha yang mengambil kesempatan emas tersebut untuk berlomba-lomba membangun Rumah Sakit yang canggih untuk mengeruk uang masyarakat.
Padahal, seharusnya kesehatan merupakan hak seluruh rakyat yang dijamu oleh pemerintah. Namun dengan mengambil cara pandang kapitalisme inilah yang akhirnya merusak dan menggerus peran negara sebagai pengurus urusan rakyat. Hari ini negara hanya bertindak sebagai regulator dan fasilitator bagi para investor dan para kapitalis.
Tidak hanya sampai disitu, mandulnya peran negara semakin nampak saat pemerintah menyerahkan urusan kesehatan pada lembaga asuransi seperti BPJS, masyarakat harus membayar premi iuran untuk mendapatkan layanan kesehatan. Sehingga, untuk memperoleh pelayanan kesehatan justru rakyat harus membiayai sendiri bukan di jamin oleh negara. Miris.
Kesehatan dalam Islam
Dalam sistem Islam, yakni khilafah menetapkan bahwa negaralah yang bertanggung jawab dalam menyediakan layanan kesehatan dan fasilitasnya secara gratis, sehingga rakyat mampu mengaksesnya dengan mudah. Selain itu, untuk menjamin kesehatan individu, negara khilafah akan melakukan langkah sebagai berikut:
Pertama membangun dan menyediakan
infrastruktur serta fasilitas kesehatan yang memadai juga menyediakan dokter serta tenaga
kesehatan ahli yang lain dan biayanya ini diambil dari kas negara (Baitul Mal) yang bersumber dari pengelolaan sumber daya alam yang dimiliki oleh negara tersebut dan tidak boleh mengalihkan
tanggung jawabnya pada pihak lain, baik swasta atau dibebankan kepada rakyat.
kedua, merisosialisasikan hidup sehat dan menciptakan lingkungan yang bersih nyaman dan menjamin kehalalan dan kehigienisan makanan dan minuman yang di konsumsi oleh masyarakat.
Inilah beberapa mekanisme Islam dlm menjaga kesehatan masyarakat dan Islam menjadikan negara bertanggung jawab agar bisa merealisasikan mekanisme ini. Oleh karena itu negara harus menjadikan Islam sebagai azas dalam mengurusi rakyat dengan menerapkan Islam secara Kaffah.
Wallau’alam Bishowwab
Views: 0

Comment here